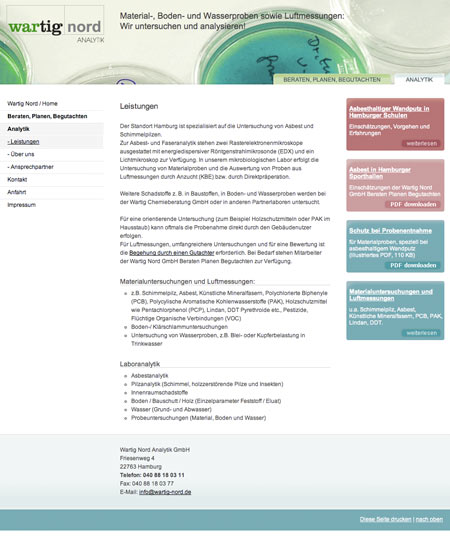

Chemieberatung unter einem Dach
Zwei Unternehmen – ein gemeinsamer Internetauftritt: zum einen das unabhängige Beratungs- und Dienstleistungsunternehmen für Gebäudesanierung, Umweltanalytik und Begutachtung. Zum anderen die Analytik von Schadstoffen in Baustoffen, Materialuntersuchungen, Bodenproben und Luftmessungen. Die gestalterische Lösung dazu entwarf IconScreen.
- Wartig Nord GmbH Beraten Planen Begutachten und Wartig Nord Analytik GmbH
- 08.2007
- Konzeption, WebDesign, HTML-Authoring
- Fotos Kopfbilder: IconScreen, istockphoto
- www.wartig.de
Aus dem Inhalt – Beispielseiten